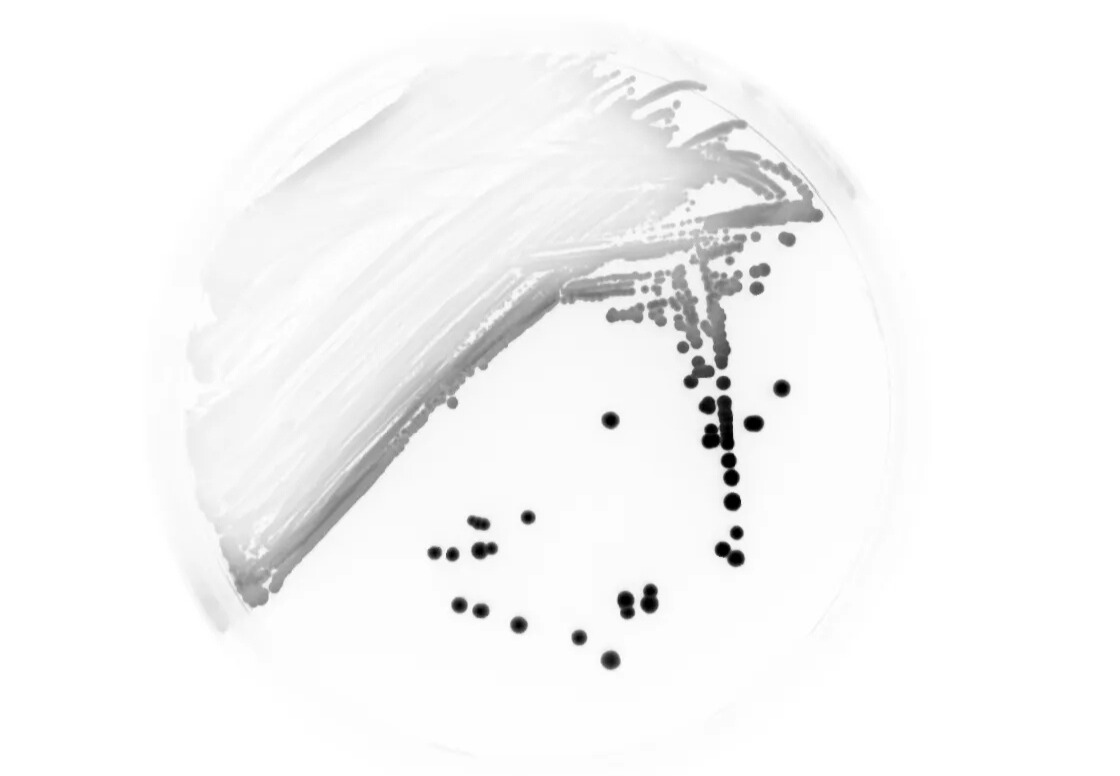
Imaging Bacterial Colonies

The image analysis software from Azure Biosystems provides a comprehensive platform for accurate image analysis of Western blots, gels, plates, and arrays. Offered through Apex Scientific in South Africa, AzureSpot Pro streamlines complex workflows and delivers reproducible, publication-ready data for scientists using demanding laboratory equipment.
Integrated Analysis Tools
AzureSpot Pro combines several modules in one intuitive package. Therefore, researchers can perform multiplex and single-channel imaging, area and profile analysis, and colony counting with exceptional accuracy. In addition, automatic lane and band detection accelerates Western blot interpretation, while manual adjustments give users complete control.
Advanced Normalization and Calibration
Furthermore, grid-based normalization supports plate and array assays, enabling reliable presence-or-absence detection. Built-in molecular-weight and quantity-calibration tools simplify total protein normalization as well as multiplex Western blot quantification. Various background-subtraction methods, including rolling ball and image rectangle, further improve data precision.
Flexible Imaging Capabilities
The software also supports large files and multi-page TIFFs. With native multiplex imaging and customizable lane boxes, scientists can analyze multiple blots or gels simultaneously. In addition, a 3D saturation model highlights signal trends before detailed evaluation, ensuring high-quality results every time.
Applications in Modern Research
Consequently, AzureSpot Pro suits chemiluminescent and fluorescent Western blots, antibody and membrane arrays, and bacterial colony imaging. Laboratories across South Africa can integrate this image analysis software into existing laboratory equipment setups for efficient data handling and interpretation.
Explore advanced imaging solutions and learn more on our Insights page. To download AzureSpot Pro directly, visit the Azure Biosystems website.